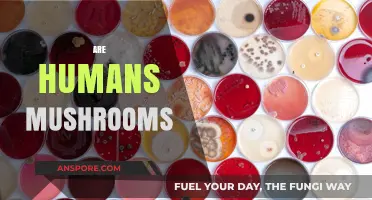
The Mushroom-Human: What Makes Us Similar?

Magic mushrooms, or mushrooms containing psilocybin, are hallucinogenic and can distort an individual's perception of reality. They have a long history of use, with evidence of their consumption by indigenous people in Central America for spiritual rituals as far back as 3000 B.C. While magic mushrooms are currently classified as illegal in many places, there is a surge of interest in their therapeutic potential for treating mental health disorders. This has sparked conversations about their addictive properties and the possibility of magic mushroom addiction.
| Characteristics | Values |
|---|---|
| Addiction risk | Low risk of addiction, but psychological dependence can develop |
| Side effects | Euphoria, hallucinations, sensory distortion, agitation, confusion, vomiting, nausea, sleeplessness, lethargy, gastrointestinal problems, headaches |
| Toxicity | Poisoning is possible if the wrong type of mushroom is picked |
| Treatment | No medication treats addiction to mushrooms or other hallucinogens |
| Use | 8.8 million Americans aged 12 and older used hallucinogens, including psilocybin, in 2023 |
| History | Used by indigenous people in Central America for healing and spiritual rituals as far back as 3000 B.C. |
| Research | Studied for their potential to treat mental illness, including substance use disorders |
| Legality | Illegal in most countries, including most states in the US |
Explore related products
What You'll Learn

Magic mushrooms are not physically addictive
Magic mushrooms, or mushrooms containing the hallucinogenic substance psilocybin, are not physically addictive. While psilocybin mushrooms are classified as a Schedule I substance by the Drug Enforcement Administration (DEA), suggesting a high risk for abuse, they do not exhibit the same addictive properties as commonly abused substances like opioids or stimulants.
Research to date indicates that psilocybin use does not typically lead to addiction. The Diagnostic and Statistical Manual of Mental Disorders, Fifth Edition (DSM-5), which is used to diagnose substance use disorders, does not include substance use criteria specifically related to psilocybin. Furthermore, current research suggests that psilocybin is not physically addictive, as no physical symptoms occur after stopping its use.
It is important to note, however, that while magic mushrooms may not be physically addictive, they can lead to psychological dependence. Psychological addiction or dependence occurs when an individual feels cognitive or emotional withdrawals from a substance. This can be dangerous, as it can cause severe anxiety and depression, potentially leading to self-harm or even suicide.
Additionally, magic mushrooms can be commonly abused with other substances, which can increase the rate of addiction and lead to physical and psychological harm. Regular use of psilocybin mushrooms can also result in significant tolerance, and there is a risk of experiencing "flashbacks" or hallucinations long after the drug was last used.
While magic mushrooms may not be physically addictive, their use can still lead to negative consequences, including psychological dependence, increased risk of injury, and potential toxic overdose when combined with other substances. It is crucial to understand the risks associated with their use and to seek professional help if struggling with substance use issues.
Mushroom Coffee: Supercharged Brew or Just a Fad?
You may want to see also

They can cause psychological dependence
While psilocybin mushrooms are not considered to be physically addictive, they can cause psychological dependence. This means that regular use can lead to feelings of cognitive or emotional withdrawal from the substance. Psychological addiction can be just as dangerous as physical addiction as it can lead to severe anxiety and depression, which may ultimately result in self-harm or even suicide.
People who use psilocybin mushrooms regularly may develop a psychological dependence and continue using them to attain the pleasurable feelings associated with their use. This can lead to somewhat problematic, compulsive patterns of use. For example, high levels of stress, a history of trauma, a co-occurring mental health or medical illness, a personal history of addiction, polysubstance abuse, and easy access to psilocybin mushrooms can increase the odds of problematic drug use and addiction.
Additionally, some people may experience flashbacks or hallucinations long after the drug was last used. These flashbacks can be intense, unpleasant, and frequent, and may last long after a person has stopped using psilocybin mushrooms. This is known as "hallucination persisting perception disorder" and is common among people who use hallucinogens.
It is important to note that the effects of psilocybin mushrooms are unpredictable and can vary widely depending on the amount taken, the intention or mindset of the user, and the physical or social environment in which they are ingested. While some people may experience positive effects such as euphoria, hallucinations, and sensory distortion, others may have a bad trip with extreme fear, anxiety, panic, or paranoia.
Cleaning Button Mushrooms: To Wash or Not?
You may want to see also

They are Schedule I drugs with no medical use
Magic mushrooms, or mushrooms containing psilocybin, are currently classified as Schedule I drugs by the Drug Enforcement Administration (DEA) in the United States. This classification means that magic mushrooms are considered to have a high risk for abuse and no accepted medical use, and any use of them is deemed abusive.
Despite the classification, there is ongoing research into the therapeutic potential of psilocybin, with scientists examining its ability to treat mental illnesses, including substance use disorders. There is a new surge of interest in understanding how psilocybin works and its potential to help treat conditions such as depression, post-traumatic stress disorder (PTSD), addiction, pain, and neurodegenerative disorders.
The National Institute on Drug Abuse (NIDA) is also supporting research into psilocybin as a potential clinical treatment for substance use disorders and other mental illnesses. Additionally, psilocybin has been used in controlled settings under the close supervision of mental health professionals to explore its potential for treating mental health issues.
However, it is important to note that psilocybin mushrooms can have adverse side effects, and their hallucinogenic effects can lead to unpredictable and potentially dangerous behaviour. Furthermore, the risk of a "bad trip" increases with higher doses or if the user experiences feelings of anxiety before taking the drug.
While magic mushrooms are not considered to exhibit the same addictive properties as commonly abused substances, they can lead to problematic and compulsive patterns of use. Psychological dependence can develop, and users may experience cognitive or emotional withdrawals, known as "flashbacks," even long after stopping use.
Mushrooms and Estrogen: What's the Connection?
You may want to see also
Explore related products

They are abused for their psychedelic effects
Psychedelic mushrooms, often referred to as magic mushrooms or simply "shrooms," are known for their mind-altering properties. These mushrooms contain the psychoactive compound psilocybin, which when ingested, can induce a range of sensory and perceptual effects, including hallucinations and an altered state of consciousness. While they have been used ritually by some indigenous cultures for centuries, in modern times, they are often abused for their recreational psychedelic effects.
When an individual consumes hallucinogenic mushrooms, the psilocybin is converted into psilocin, which is responsible for the hallucinogenic effects. These effects can include distorted perceptions of time and space, intensified emotions and experiences, and sensory hallucinations, such as seeing or hearing things that are not there. The "trip" or hallucinogenic experience can last for several hours and is often described as an intense and profound journey into the subconscious.
Those who abuse hallucinogenic mushrooms often seek these intense and novel experiences. They may be attracted to the idea of exploring their mind, enhancing creativity, or achieving a sense of spiritual enlightenment. In some cases, individuals may also use mushrooms in an attempt to self-medicate mental health issues, such as depression or anxiety, believing that the psychedelic experience can provide insight and relief. However, it is important to note that while psilocybin is currently being studied for its potential therapeutic benefits under controlled conditions, unsupervised use carries risks.
The effects of hallucinogenic mushrooms are highly variable and depend on various factors, including the type and dosage of mushrooms consumed, the individual's expectations and surroundings, and their emotional state. While some users may experience pleasant and insightful "trips," others may encounter unpleasant and distressing episodes known as "bad trips." During a bad trip, an individual may experience anxiety, paranoia, panic, and even psychotic episodes with an impaired sense of reality. These negative experiences can be frightening and have the potential to lead to impulsive or dangerous behavior.
It is crucial to understand that while hallucinogenic mushrooms may not lead to physical dependence or addiction in the same way as other substances, they can certainly be abused and misused. The recreational use of these mushrooms solely for their psychedelic effects can have risks and negative consequences. It is always advisable to approach these substances with caution and to seek professional guidance if one intends to explore their potential therapeutic benefits. Responsible and informed use is essential to minimize potential harm and ensure a positive and safe experience.
Fresh Mushrooms: Sulfites or Not?
You may want to see also

They are being studied for therapeutic use
Hallucinogenic mushrooms, or "magic mushrooms", contain psilocybin, a hallucinogenic substance. While the mushrooms themselves are not considered addictive, regular use may lead to tolerance and can cause unpredictable and dangerous behaviour. There is also a risk of accidentally consuming poisonous mushrooms.
Despite this, psilocybin is being studied for its therapeutic potential. The National Institute on Drug Abuse (NIDA) is researching its effectiveness in treating substance use disorders and other mental illnesses. There is also evidence that psilocybin may be an effective treatment for depression, anxiety disorders, and post-traumatic stress disorder (PTSD).
The Johns Hopkins Center for Psychedelic and Consciousness Research has reported that a large dose of psilocybin, in the context of a cognitive behavioural therapy treatment program, helped longtime smokers quit the habit. In another small double-blind study, researchers found that a single large dose of psilocybin provided considerable relief for up to six months for people suffering from cancer-related anxiety or depression.
In addition, an online survey of over 300 people with Alcohol Use Disorder reported reduced alcohol consumption after taking a psychedelic drug such as psilocybin. NIDA is also funding a large, multi-site study on the effectiveness of psilocybin versus a nicotine patch, in combination with therapy, to help people stop smoking.
Psilocybin has been used for thousands of years in mushroom-worshipping ceremonies in old-world cultures. Indigenous people in Central America have also used them for healing and spiritual rituals as far back as 3000 B.C.
Mushroom Mixing: Can Different Types Grow Together?
You may want to see also
Frequently asked questions
Research suggests that hallucinogenic mushrooms are not typically addictive. However, they can be abused and lead to psychological dependence, especially when used with other substances.
Side effects of hallucinogenic mushroom use include increased heart rate and blood pressure, agitation, confusion, nausea, vomiting, and hallucinations. Some people may also experience adverse effects such as extreme fear, anxiety, panic, paranoia, and what is known as a "bad trip".
A "bad trip" can be a stressful and scary experience, leading to negative side effects such as anxiety, paranoia, aggression, risky behaviours, and changes in thoughts and emotions.
There is ongoing research into the therapeutic potential of hallucinogenic mushrooms, also known as psilocybin or magic mushrooms, for treating substance use disorders and other mental illnesses. However, it is crucial to note that the use of hallucinogenic mushrooms currently carries risks and is illegal in most countries.